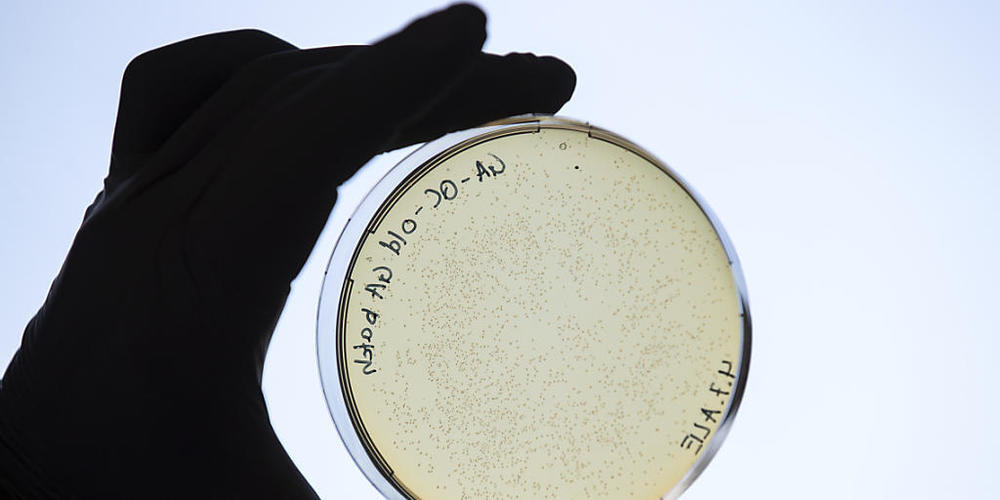
Auch für die Schweiz ist es wichtig, dass die EU sich rechtzeitig auf ihren mehrjährigen Finanzrahmen einigen kann. Denn gelingt der EU das nicht, dann erhält auch das für die Schweiz wichtige und interessante EU-Forschungsprogramm "Horizon Europe...

Konkret wird über die Verknüpfung der Auszahlung von EU-Gelder an die Einhaltung von Rechtsstaatsprinzipien gestritten. Ungarn und Polen blockierten deshalb den mehrjährigen Finanzrahmen (2021-2027) mit einem Volumen von gut 1,8 Billionen Euro.
Findet sich kein Kompromiss - denn auch das EU-Parlament muss noch seine Zustimmung geben -, wird die EU ab dem 1. Januar mit einem Notbudget auskommen müssen. Dieses wäre rund 15 Prozent kleiner als das ordentliche Budget.
Nicht mehr finanziert würden dann alle neuen Programme. Davon betroffen wären die für die Schweiz wichtigen und interessanten EU-Programme wie "Horizon Europe", "Erasmus plus", "Kreatives Europa" und Interreg.
Forschung und Bildung
Die Schweiz, die sich am aktuellen EU-Forschungsprogramm "Horizon 2020" beteiligt, möchte auch am Nachfolgeprogramm "Horizon Europe" teilnehmen, dem voraussichtlich für die kommenden sieben Jahre 85 Milliarden Euro zur Verfügung stehen werden.
Auf Schweizer Seite gibt es bereits ein Verhandlungsmandat. Bereitgestellt sind auch schon die finanziellen Mittel dafür in der Höhe von 6,15 Milliarden Franken.
Ebenfalls strebt der Bund eine Beteiligung der Schweiz am Studentenaustauschprogramm "Erasmus plus" an, das 26,2 Milliarden Euro erhalten soll. Doch auf Schweizer Seite gibt es noch kein Verhandlungsmandat. Das gleiche gilt für den finanziellen Beitrag.
Kultur und Regionen
Mit dem Rahmenprogramm "Kreatives Europa" will die EU die Film- sowie und die Kultur-und Kreativbranche fördern. Sie sieht dafür voraussichtlich 2,2 Milliarden Euro vor. Auch bei diesem Programm strebt die Schweiz eine Teilnahme an. Doch auch hier gibt es seitens der Schweiz noch kein Verhandlungsmandat.
Wichtig für die Schweiz sind ausserdem die Interreg-Programme der EU, die zum Ziel haben, die regionale, grenzüberschreitende Entwicklung zu fördern. Dafür plant die EU voraussichtlich neun Milliarden Euro ein.
Doch bei Interreg verhandelt nicht der Bund über eine Teilnahme - es braucht damit auch kein Verhandlungsmandat. Vielmehr organisieren und finanzieren sich die Kantone mit den Regionen aus der EU selber.
Bei all diesen EU-Programmen, an denen die Schweiz teilnehmen möchte, ist zurzeit jedoch nicht klar, ob die EU eine Verbindung zum institutionellen Rahmenabkommen machen wird. Bei Programmen wie "Horizon Europe" dürften ausserdem die Verhandlungen zwischen Grossbritannien und der EU einen Einfluss auf die Schweiz haben. Es gibt also noch einige Fragezeichen.